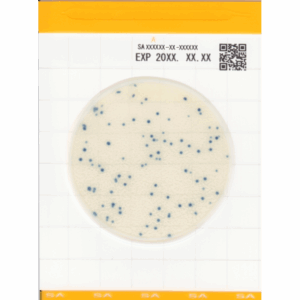
Easy Plate SA Staphylococcus aureus

A mostrar todos os 19 resultados
-

-

-

-

-
-

-

-

-

Lucipac A3 Superfícies (Pré-humedecida)
295,00 € (preço sem IVA)CompararLucipac A3 Superfícies (Pré-humedecida) é um kit de teste altamente sensível para validação de limpeza de superfícies. Deteção A3 (ATP + ADP + AMP) Sensibilidade insuperável. Amostragem rápida e fácil. Pré-humedecidas. Certificado AOAC (Certificado PTM Nº 112201). Smear não deixa produtos químicos na superfície. Acondicionamento: 2 a 8 ºC (não congelar). Validade: 15 meses (após…
-

Lucipac A3 Superfícies
295,00 € (preço sem IVA)CompararLucipac A3 Superfícies é um kit de teste altamente sensível para validação de limpeza de superfícies. Deteção A3 (ATP + ADP + AMP) Sensibilidade insuperável. Amostragem rápida e fácil. Certificado AOAC (Certificado PTM Nº 051901). Smear não deixa produtos químicos na superfície. Acondicionamento: 2 a 8 ºC (não congelar). Validade: 15 meses (após data de…
-

-

Kit de verificação da higiene das mãos
41,50 € – 50,00 €Price range: 41,50 € through 50,00 € (preço sem IVA)Conjunto de gel + lanterna para verificação de higienização das mãos. Consegue ver microrganismos sem um microscópio? Não. Mas, com a magia de pós fluorescentes UV, é possível (e fácil) ver como os micróbios agem. Veja para onde vão, como os pode lavar. Glitterbug é a analogia perfeita para micróbios, que faz com que os…
Ver opções This product has multiple variants. The options may be chosen on the product pageComparar -

-

-

HygieneChek™ Plus – Lâminas de contato/1 meio de cultura
22,10 € – 55,59 €Price range: 22,10 € through 55,59 € (preço sem IVA)Ver opções This product has multiple variants. The options may be chosen on the product pageComparar -

HygieneChek™ Plus – Lâminas de contato/2 meios de cultura
22,10 € (preço sem IVA)Ver opções This product has multiple variants. The options may be chosen on the product pageComparar -

Clean Trace
207,50 € – 395,85 €Price range: 207,50 € through 395,85 € (preço sem IVA)Clean Trace: método simples, rápido e confiável de verificar a remoção de resíduos de proteína após a limpeza e identifica rapidamente a contaminação. Dispositivo de uso único que deteta proteínas em resíduos de alimentos e outras. Também deteta outras substâncias redutoras presentes em resíduos de alimentos. A cor altera-se com o tempo, por isso desconsidere…
Ver opções This product has multiple variants. The options may be chosen on the product pageComparar -

-



